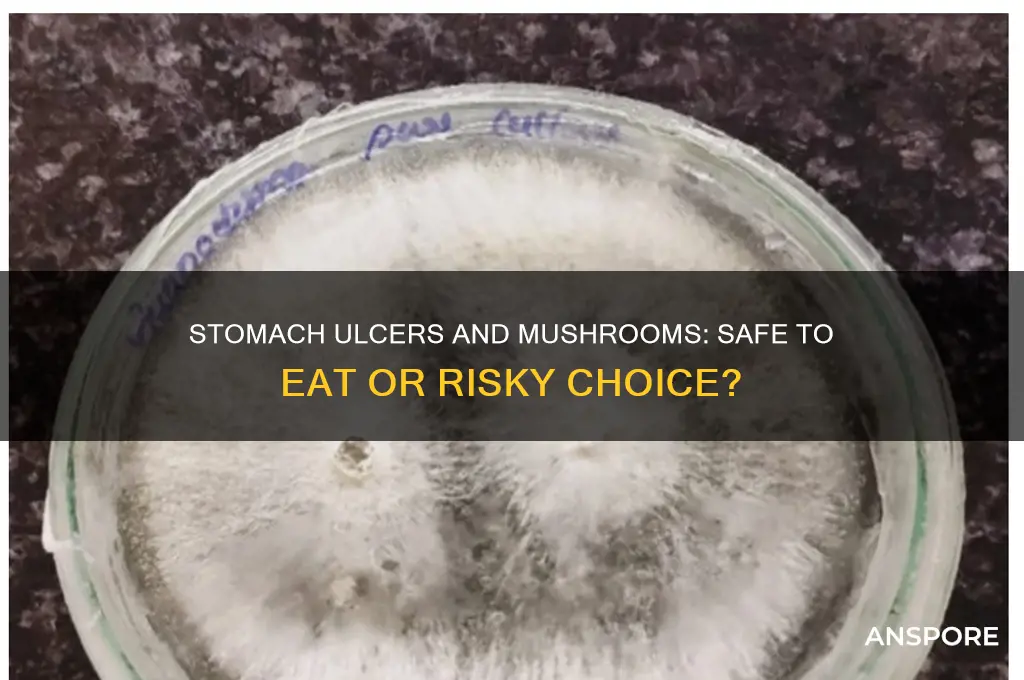
can i eat mushrooms with stomach ulcer

If you have a stomach ulcer, it’s crucial to be mindful of your diet to avoid aggravating the condition. Mushrooms, while generally healthy and nutrient-rich, can be problematic for individuals with stomach ulcers due to their high fiber content and potential to stimulate acid production. Additionally, some types of mushrooms may be difficult to digest, which could irritate the ulcerated area. It’s advisable to consult a healthcare professional before including mushrooms in your diet, as they can provide personalized guidance based on the severity of your ulcer and your overall health. Opting for well-cooked, low-fiber varieties in moderation might be safer, but avoiding them altogether may be the best approach during the healing phase.
| Characteristics | Values |
|---|---|
| General Recommendation | Mushrooms are generally considered safe for people with stomach ulcers, but individual tolerance may vary. |
| Nutritional Value | Low in fat, high in fiber, vitamins (B, D), and minerals (selenium, potassium), which can support overall health. |
| Potential Benefits | Some mushrooms (e.g., shiitake, maitake) have anti-inflammatory and immune-boosting properties that may aid healing. |
| Potential Risks | Certain mushrooms (e.g., raw or wild varieties) may irritate the stomach lining or cause digestive discomfort in sensitive individuals. |
| Preparation Matters | Cooked mushrooms are easier to digest than raw ones; avoid frying in excessive oil or adding spicy seasonings. |
| Portion Control | Consume in moderation; large quantities may trigger discomfort in some people with ulcers. |
| Individual Sensitivity | Tolerance varies; monitor symptoms and avoid if mushrooms worsen ulcer-related pain or bloating. |
| Medical Advice | Consult a healthcare provider or dietitian for personalized advice based on your specific condition. |
| Avoid Wild Mushrooms | Wild mushrooms can be toxic and should be avoided unless properly identified by an expert. |
| Probiotic Content | Some mushrooms contain prebiotics that may support gut health, but effects on ulcers are not well-studied. |
Explore related products
$19.99 $21.99
What You'll Learn
- Safe Mushroom Types: Identify non-irritating mushrooms suitable for consumption with stomach ulcers
- Preparation Methods: Learn gentle cooking techniques to minimize ulcer irritation
- Portion Control: Understand appropriate serving sizes to avoid discomfort
- Symptom Monitoring: Watch for signs of worsening ulcers after mushroom consumption
- Doctor Consultation: Seek professional advice before adding mushrooms to your ulcer diet

Safe Mushroom Types: Identify non-irritating mushrooms suitable for consumption with stomach ulcers
Stomach ulcers demand a diet that minimizes irritation, and mushrooms, while nutritious, can sometimes exacerbate discomfort. However, not all mushrooms are created equal. Certain varieties, when prepared correctly, can be safely incorporated into an ulcer-friendly diet. The key lies in selecting mushrooms with low acidity and mild flavors, avoiding those known to stimulate acid production or cause digestive distress.
Analyzing Mushroom Types: Shiitake, maitake, and oyster mushrooms are excellent choices due to their gentle nature. These varieties are rich in beta-glucans, which have anti-inflammatory properties that may aid in ulcer healing. Conversely, avoid wild mushrooms like morels or chanterelles, as their complex compounds can irritate the stomach lining. Portobello and cremini mushrooms, while generally safe, should be consumed in moderation due to their slightly higher acidity compared to the aforementioned varieties.
Preparation Matters: How you prepare mushrooms significantly impacts their suitability for ulcer sufferers. Steaming or boiling mushrooms reduces their natural acidity and makes them easier to digest. Avoid frying or sautéing in oil, as high-fat cooking methods can trigger acid reflux. Additionally, marinating mushrooms in acidic dressings or sauces should be avoided, as this can counteract their otherwise mild nature.
Incorporating Mushrooms Safely: Start with small portions (around 50-75 grams per serving) to gauge tolerance. Gradually increase intake if no discomfort occurs. Pair mushrooms with ulcer-friendly foods like oatmeal, lean proteins, and steamed vegetables for a balanced meal. Remember, individual sensitivities vary, so consult a healthcare professional before making significant dietary changes.
Beyond Mushrooms: While safe mushroom types can be a valuable addition to an ulcer diet, they are not a cure. Prioritize a holistic approach that includes stress management, adequate sleep, and avoiding trigger foods like caffeine, alcohol, and spicy dishes. By combining mindful mushroom selection with overall lifestyle adjustments, individuals with stomach ulcers can enjoy the nutritional benefits of these fungi without compromising their health.
Are Expired Canned Mushrooms Safe to Eat? A Guide
You may want to see also

Preparation Methods: Learn gentle cooking techniques to minimize ulcer irritation
Cooking mushrooms for someone with a stomach ulcer requires a delicate touch to avoid exacerbating symptoms. High heat and aggressive methods like frying can increase acidity and irritation, making gentle techniques essential. Opt for steaming, boiling, or simmering, which preserve nutrients while minimizing the production of compounds that might aggravate the stomach lining. These methods also help break down tough fibers, making mushrooms easier to digest.
Consider the steaming method as a prime example. Place sliced mushrooms in a steamer basket over simmering water for 5–7 minutes. This retains their texture and flavor without adding fats or oils that could trigger discomfort. Alternatively, boiling mushrooms in a mild broth for 8–10 minutes creates a soothing, digestible dish. For added flavor, incorporate ulcer-friendly herbs like ginger or turmeric, known for their anti-inflammatory properties. Avoid acidic ingredients like tomatoes or vinegar, which can worsen irritation.
Another effective technique is simmering mushrooms in a gentle soup. Combine mushrooms with low-acid vegetables like carrots, zucchini, or spinach in a broth made from bone or vegetable stock. Simmer on low heat for 15–20 minutes, allowing flavors to meld without overcooking. This method not only softens the mushrooms but also creates a nourishing meal that’s easy on the stomach. For those with severe ulcers, strain the broth and consume it separately to further reduce fiber intake.
Caution is key when experimenting with preparation methods. Avoid sautéing or grilling mushrooms, as these methods often require oils or high temperatures that can increase acidity and irritation. Additionally, limit the use of spices like black pepper or chili, which may aggravate the ulcer. Always test small portions of gently cooked mushrooms to gauge tolerance before incorporating them into larger meals.
In conclusion, gentle cooking techniques like steaming, boiling, and simmering are ideal for preparing mushrooms for individuals with stomach ulcers. These methods prioritize digestibility and minimize irritation, ensuring that mushrooms can be enjoyed without discomfort. By pairing these techniques with ulcer-friendly ingredients and avoiding harsh cooking practices, you can create meals that are both nourishing and safe.
Are Brown-Spotted Mushrooms Safe to Eat? A Quick Guide
You may want to see also

Portion Control: Understand appropriate serving sizes to avoid discomfort
Eating mushrooms with a stomach ulcer requires careful consideration, especially when it comes to portion control. Overeating, even of ulcer-friendly foods, can exacerbate symptoms like bloating, pain, or acid reflux. A single serving of mushrooms (about 1 cup raw or ½ cup cooked) is generally well-tolerated by most individuals, but those with ulcers should start with smaller amounts—think ¼ to ½ cup—to gauge their body’s response. This cautious approach minimizes the risk of overloading the digestive system, which is already compromised by the ulcer.
Portion control isn’t just about quantity; it’s also about frequency. While mushrooms are nutrient-dense and low in acidity, consuming them in large amounts multiple times a day can still irritate the stomach lining. Aim to include mushrooms as part of a balanced meal rather than as the main component. For instance, add a small handful of sautéed mushrooms to a vegetable stir-fry or omelet instead of eating a mushroom-heavy dish like a creamy mushroom soup. This ensures you benefit from their nutritional value without overwhelming your stomach.
The method of preparation also plays a role in portion control. Raw mushrooms can be harder to digest, so cooking them—whether steamed, grilled, or sautéed—can make them gentler on the stomach. However, avoid heavy sauces or oils, as these can increase the overall fat content of the meal, potentially triggering discomfort. Stick to light cooking methods and pair mushrooms with easy-to-digest foods like steamed vegetables or lean proteins to create a stomach-friendly portion.
For individuals with severe ulcers or heightened sensitivity, even small portions of mushrooms might cause issues. In such cases, consider incorporating mushrooms in minimal amounts—as little as 2–3 sliced mushrooms per meal—and monitor how your body reacts. If no discomfort occurs, you can gradually increase the portion size over time. This incremental approach allows you to enjoy mushrooms without risking ulcer symptoms, ensuring portion control aligns with your body’s unique needs.
Ultimately, mastering portion control with mushrooms involves listening to your body and adjusting based on its feedback. Start small, prepare them simply, and integrate them into balanced meals. By doing so, you can enjoy the nutritional benefits of mushrooms while minimizing the risk of discomfort, making them a viable addition to an ulcer-friendly diet.
Can Dogs Safely Eat Trumpet Mushrooms? A Pet Owner's Guide
You may want to see also
Explore related products

Symptom Monitoring: Watch for signs of worsening ulcers after mushroom consumption
Mushroom consumption can exacerbate stomach ulcers in some individuals, making symptom monitoring crucial after ingestion. If you’ve eaten mushrooms and have a history of ulcers, pay close attention to changes in abdominal pain. Ulcer pain typically feels like a burning or gnawing sensation in the upper abdomen, often worsening on an empty stomach. After consuming mushrooms, note if the pain intensifies, becomes more frequent, or radiates to your back—these could indicate irritation or inflammation of the ulcerated area.
Next, monitor for gastrointestinal bleeding, a severe complication of worsening ulcers. Symptoms include black, tarry stools (melena) or vomiting blood (hematemesis). Even small amounts of blood in stool can signal a problem. If you notice these signs after eating mushrooms, seek immediate medical attention, as they may indicate a perforated or bleeding ulcer. Keep a symptom journal to track changes, noting the timing and severity of any discomfort or unusual symptoms.
Another critical symptom to watch for is persistent nausea or vomiting, especially if it occurs repeatedly after mushroom consumption. This could suggest increased stomach acid production or irritation of the ulcer site. If vomiting is severe or you’re unable to keep food down, dehydration becomes a risk, further complicating your condition. Stay hydrated with small sips of water and avoid mushrooms entirely if nausea persists.
Finally, observe for systemic signs of infection or complications, such as fever, unexplained weight loss, or fatigue. These symptoms may indicate that the ulcer has worsened or become infected, particularly if paired with abdominal pain. If mushrooms seem to trigger these responses, eliminate them from your diet and consult a healthcare provider. Practical tips include avoiding raw or fried mushrooms, as these forms may be harder to digest and more likely to irritate ulcers. Always err on the side of caution and prioritize symptom monitoring to prevent complications.
Deadly Fungi: Can Poisonous Mushrooms Be Fatal to Humans?
You may want to see also

Doctor Consultation: Seek professional advice before adding mushrooms to your ulcer diet
Stomach ulcers demand a cautious approach to diet, and mushrooms, while nutritious, can be a gray area. Their fiber content, though beneficial for gut health in general, might irritate sensitive ulcer sites. Before incorporating mushrooms into your meals, consulting a doctor is crucial. They can assess your specific ulcer condition, considering factors like severity, location, and underlying causes. This personalized evaluation ensures that dietary choices, including mushroom consumption, align with your healing process.
A doctor's guidance extends beyond a simple "yes" or "no" regarding mushrooms. They can advise on suitable mushroom varieties, preparation methods (cooked vs. raw), and portion sizes. For instance, cooked mushrooms are generally easier to digest than raw ones. Additionally, they can recommend incorporating mushrooms into a balanced diet that supports ulcer healing, potentially including foods rich in probiotics and antioxidants. This holistic approach, tailored to your individual needs, maximizes the benefits of mushrooms while minimizing potential risks.
Canned Mushrooms and Fiber: Unveiling Their Nutritional Benefits
You may want to see also
Frequently asked questions
It’s generally best to avoid mushrooms if you have a stomach ulcer, as they can be difficult to digest and may irritate the stomach lining.
Most mushrooms, especially raw or fried ones, can aggravate ulcers. However, well-cooked and small amounts of certain types (like button mushrooms) may be tolerated by some individuals.
Yes, mushrooms can potentially worsen symptoms like pain, bloating, and acidity due to their fibrous nature and potential to increase stomach acid production.
It’s best to consult a doctor or dietitian, but generally, mushrooms should be avoided until the ulcer heals. Some people may tolerate cooked, low-fiber varieties in moderation.
Avoid mushrooms until your doctor confirms the ulcer has healed, as they can hinder the healing process and cause discomfort. This period typically varies depending on individual health and treatment.











































